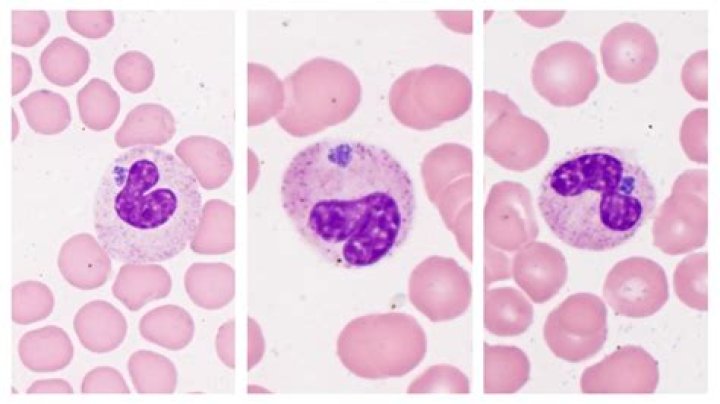
Can humans get anaplasmosis?

How does rugal end?
Score: 4.1/5 (40 votes) After a brutal fight, Mi-na is stabbed in the stomach and it appears to be an extremely deep wound. Thankfully, Tae-woong shows u...

Score: 4.1/5 (40 votes) After a brutal fight, Mi-na is stabbed in the stomach and it appears to be an extremely deep wound. Thankfully, Tae-woong shows u...

Score: 4.9/5 (64 votes) IDC starts in the cells that line a milk duct in the breast. From there, the cancer breaks through the wall of the duct, and grow...
Score: 4.4/5 (9 votes) Although people of any age can get anaplasmosis, it tends to be most severe in the aging or immune-compromised. Severe complicatio...

Score: 4.7/5 (66 votes) Did he also serve in the military? Ivan Moody Ivan Moody Early lifeGrowing up, he lived in several smaller cities in the area, in...

Score: 4.7/5 (30 votes) The heart is dorsal to the sternum. The knee is proximal to the thigh. What is dorsal to the sternum? Posterior (Dorsal) Towards ...

Score: 4.4/5 (15 votes) : having no fault : irreproachable faultless workmanship. What means faultlessly? adjective. without fault, flaw, or defect; perf...

Score: 4.5/5 (6 votes) In the U.S., ICD-10 is split into two systems: ICD-10-CM (Clinical Modification), for diagnostic coding, and ICD-10-PCS (Procedure...

Score: 5/5 (37 votes) Mahabharat movie is an upcoming 3D movie, that is going to be directed by the critically acclaimed Indian director, SS Rajamouli. ....

Score: 4.7/5 (36 votes) If you recce an area, you visit that place in order to become familiar with it. People usually recce an area when they are going ...

Score: 4.3/5 (48 votes) Opossums are omnivorous and are beneficial to humans because they cause very little damage and they consume undesirable insects, ...

Score: 4.2/5 (54 votes) verb (used with object), pic·tur·ized, pic·tur·iz·ing. to represent in a picture, especially in a motion picture; make a picture ...

Score: 4.1/5 (36 votes) It only has 69 calories per ounce and no carbohydrates thanks to the distillation process. How much sugar is in a shot of tequila...

Score: 4.5/5 (54 votes) The possum is actually a tree-climbing marsupial that lives in Australia, and a distant cousin to the North American, opossum. no...